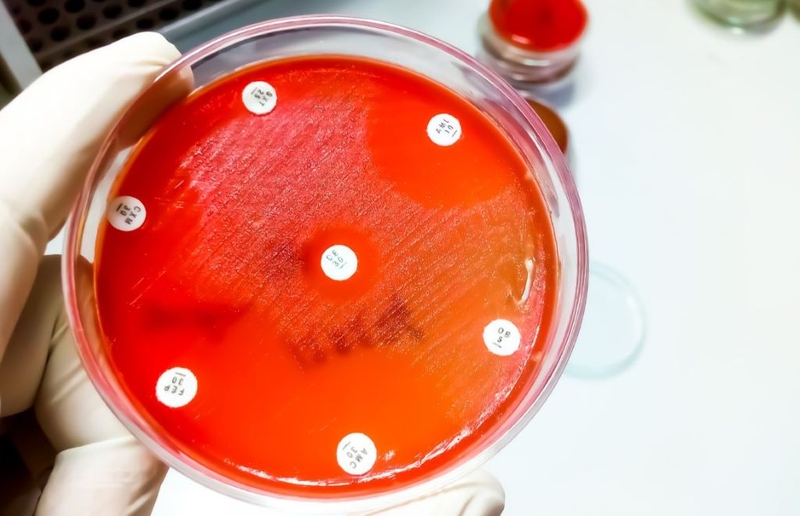
Kháng sinh đồ: Đối tượng chỉ định, cách thực hiện và ý nghĩa của phương pháp 3

Tốt nghiệp Đại Học Dược Hà Nội - chuyên môn Dược lâm sàng. Hiện đang là giảng viên cho Dược sĩ tại Nhà thuốc Long Châu.
Phương Nhi
22/10/2025
Mặc định
Lớn hơn
Kháng sinh đồ là chỉ định quan trọng cần được thực hiện trước khi điều trị nhiễm khuẩn. Kết quả phương pháp này giúp bác sĩ lựa chọn loại thuốc kháng sinh hiệu quả nhất. Hãy cùng Nhà thuốc Long Châu tìm hiểu về kỹ thuật này cùng đối tượng cần thực hiện nhé!
Theo Tổ chức Y tế Thế giới, hiện tượng kháng kháng sinh đang ngày càng gia tăng trên toàn thế giới, trong đó có Việt Nam. Điều này đồng nghĩa với việc càng ngày càng ít loại kháng sinh hiệu quả để điều trị nhiễm khuẩn. Bởi vậy, chuyên gia khuyến cáo cần thực hiện kháng sinh đồ với mọi đối tượng nghi ngờ nhiễm trùng.
Kháng sinh đồ là một phương pháp quan trọng trong lĩnh vực y học, giúp xác định mức độ nhạy cảm của kháng sinh đối với vi khuẩn gây bệnh, đồng thời cung cấp thông tin quan trọng về sự đề kháng của vi khuẩn trước các loại kháng sinh cụ thể. Đây là một công cụ quan trọng giúp quản lý và điều trị các bệnh nhiễm trùng một cách hiệu quả.
Kháng sinh đồ thường được thực hiện bằng cách kiểm tra mẫu vi khuẩn với các loại kháng sinh khác nhau. Mục tiêu của quá trình này là xác định loại kháng sinh nào hiệu quả nhất đối với vi khuẩn đó. Quá trình này giúp bác sĩ lựa chọn loại kháng sinh phù hợp để điều trị bệnh nhiễm trùng một cách chính xác, hiệu quả nhất.
Trong số nhiều phương pháp kháng sinh đồ, phương pháp khoanh giấy kháng sinh khuếch tán trong thạch là một trong những phương pháp phổ biến nhất, được sử dụng rộng rãi. Kỹ thuật này đơn giản và tiện lợi, giúp phân loại vi khuẩn cũng như đánh giá mức độ đáp ứng của chúng đối với các loại thuốc kháng sinh khác nhau.

Kháng sinh đồ là một công cụ quan trọng giúp xác định độ nhạy cảm của vi khuẩn đối với kháng sinh bởi vậy nên chúng đóng vai trò quyết định trong việc chọn lựa liệu pháp điều trị.
Trong quá trình quản lý nhiễm khuẩn, đối tượng cần làm kháng sinh đồ không chỉ là những người bệnh nghi ngờ nhiễm khuẩn mà còn bao gồm những trường hợp đặc biệt như bệnh nhân có sốt, chưa sử dụng kháng sinh khi mới nhập viện.
Đầu tiên, việc làm kháng sinh đồ đối với tất cả các trường hợp bệnh nhân nghi ngờ nhiễm khuẩn là cực kỳ quan trọng. Điều này bao gồm những bệnh nhân có các triệu chứng nhiễm khuẩn như sưng, đỏ, đau tại vị trí nào đó trên cơ thể và có khả năng cao là do vi khuẩn.
Bên cạnh đó, nhóm đối tượng có triệu chứng sốt mà chưa sử dụng kháng sinh đặc biệt cần chú ý vì người bệnh chưa được tiếp xúc với kháng sinh trước đó. Việc làm kháng sinh đồ ở đối tượng này giúp xác định chính xác mức độ nhạy cảm của vi khuẩn đối với các loại kháng sinh, từ đó đưa ra liệu pháp điều trị hiệu quả.
Ngược lại, việc sử dụng kháng sinh quá mức hoặc lựa chọn sai loại thuốc có thể tạo ra nguy cơ kháng thuốc, khiến cho vi khuẩn trở nên khó điều trị với các loại kháng sinh thông thường. Việc làm kháng sinh đồ giúp đề phòng tình trạng này.
Bởi kết quả kháng sinh đồ giúp bác sĩ lựa chọn kháng sinh phù hợp với vi khuẩn gây bệnh, giảm rủi ro sử dụng những loại kháng sinh không cần thiết, đồng thời tăng hiệu suất điều trị.
Chính vì vậy, cán bộ y tế cần ưu tiên làm kháng sinh đồ trong các trường hợp người bệnh nghi ngờ nhiễm khuẩn. Điều này không chỉ hỗ trợ quyết định điều trị hiệu quả mà còn đóng góp vào nỗ lực kiểm soát, ngăn chặn sự phát triển của tình trạng kháng thuốc kháng sinh.

Phương pháp khoanh giấy kháng sinh khuếch tán trong thạch hay còn gọi là phương pháp Kirby - Bauer là một quy trình đơn giản, được áp dụng phổ biến, thường được thực hiện ở phòng xét nghiệm với quy mô khác nhau. Dưới đây là các bước tiến hành chi tiết của phương pháp này, cụ thể:
Dựa trên kết quả kháng sinh đồ, bác sĩ lựa chọn các loại kháng sinh có độ nhạy cao để đưa ra phác đồ điều trị cho bệnh nhân. Tuy đây là phương pháp hiệu quả giúp xác định loại thuốc kháng sinh nhưng cần lưu ý đến các yếu tố dẫn đến sai sót như chất lượng môi trường thạch, tính thuần khiết của vi khuẩn, đặc biệt là khả năng thấm của khoanh giấy chứa kháng sinh.
Kháng sinh đồ là một công cụ quan trọng trong việc xác định, đánh giá mức độ nhạy cảm của vi khuẩn đối với kháng sinh. Quá trình này giúp quản lý bệnh nhiễm khuẩn, từ chẩn đoán đến lựa chọn liệu pháp điều trị, bao gồm:

Thông qua bài viết trên, Nhà thuốc Long Châu xin gửi tới quý độc giả thông tin về kháng sinh đồ. Khi quản lý bệnh nhiễm khuẩn, kháng sinh đồ không chỉ là một công cụ chẩn đoán mà còn là chiến lược quan trọng giúp hướng dẫn điều trị, ngăn chặn sự gia tăng của tình trạng kháng kháng sinh. Ý nghĩa của phương pháp này không chỉ giới hạn trong việc lựa chọn loại kháng sinh mà còn nằm ở khả năng duy trì độ hiệu quả của thuốc trong điều trị bệnh nhiễm khuẩn.
Xem thêm:
:format(webp)/KF_1b_LIQ_Tx_J_Pb27_Vsh90_QN_6b_Xz_OB_Jo_U_f0e2294e2e.png)
Dược sĩ Đại họcNguyễn Chí Chương
Tốt nghiệp Đại Học Dược Hà Nội - chuyên môn Dược lâm sàng. Hiện đang là giảng viên cho Dược sĩ tại Nhà thuốc Long Châu.